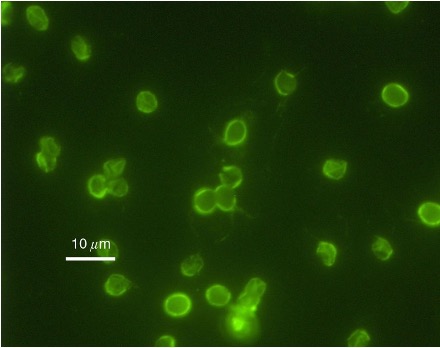
term image

Lecture 10- Introduction to Protozoa. Ciliates, Giardia, Elmeria, Cystolspora, and Cryptosporidium (Identification)
1/42
There's no tags or description
Looks like no tags are added yet.
Name | Mastery | Learn | Test | Matching | Spaced | Call with Kai |
|---|
No analytics yet
Send a link to your students to track their progress
43 Terms

Pig is reservoir, can be found in other animals and humans (zoonotic).
Balantidium coli (mammals); trophozoites
~30–150 x 25–120 µm (largest protozoan parasite of humans).

Pig is reservoir, can be found in other animals and humans (zoonotic).
Balantidium coli (mammals); cysts
Smaller, spherical cysts (~40-70 x 40-60 µm).

Ciliates of Fish - “Ich” or “Ick” or “White spot disease”

Ciliates of Fish - “Ich” or “Ick” or “White spot disease”

Giardia spp.;
Trophozoites (~9-21 X 5-15 µm): Pear-shaped, 2x nuclei, 4x pair of flagella, 2x median bodies, a ventral adhesive disk.
Active, feeding stage that inhabits the small intestine.

Giardia spp.;
Cysts (~8-15 X 5-10 µm): Ovoid to ellipsoid, possess a two-layered wall with 2–4 nuclei and internal fibrils (axonemes).
Persistent stage responsible for transmission (resistant to chlorine in water systems).

Giardia spp.;
Trophozoites (~9-21 X 5-15 µm): Pear-shaped, 2x nuclei, 4x pair of flagella, 2x median bodies, a ventral adhesive disk.
Active, feeding stage that inhabits the small intestine.

Giardia duodenalis:
Trophozoites (found in small intestine and diarrhea);
~9–21 x 5–15 µm.
Pear-shaped, 2x nuclei, 4x pair of flagella, 2x median bodies, a ventral adhesive disk.
Cysts (found in fecal floatations usually);
~8-15 X 5-10 µm.
Ovoid to ellipsoid, possess a two-layered wall with 2–4 nuclei and internal fibrils (axonemes).

Dogs (C. canis*), Pigs (C. suis*), Calves & Lambs (C. parvum*), Birds (C. meleagridis),
Humans (C. hominis & C. cuniculus, and *) - most important.
Cryptosporidium spp. (Cryptosporidiosis);
Oocysts (shed in feces);
~4-6 X 4.5-7 µm - No micropyle or micropylar cap, inner and outer walls are sealed closed by the suture.
Sporulated oocyst containing 1x0x4 architecture (0x sporocysts X 4x sporozoites total).

Dogs (C. canis*), Pigs (C. suis*), Calves & Lambs (C. parvum*), Birds (C. meleagridis),
Humans (C. hominis & C. cuniculus, and *) - most important.
Cryptosporidium spp. (Cryptosporidiosis);
Most species oocysts measuring ~ 4-6 X 4.5-7 µm.

Dogs (C. canis*), Pigs (C. suis*), Calves & Lambs (C. parvum*), Birds (C. meleagridis),
Humans (C. hominis & C. cuniculus, and *) - most important.
Cryptosporidium spp. (Cryptosporidiosis);
Most species oocysts measuring ~ 4-6 X 4.5-7 µm.

Dogs & Cats, Pigs (C. suis), Humans (C. belli), Nonhuman primates (C. arctopitheci,C. callimico, and C. scorzai).
Most species oocysts measuring ~ 20-53 X 10-43 µm (animal ones being larger than C. belli).
Cystoisospora spp. (Cystoisosporiasis);
Oocysts (shed in feces);
~20-53 X 10-43 µm - Broadly oval, colorless to pinkish, no micropyle or micropylar cap.
Sporulated containing 1x2x4 architecture (2x sporocysts X 4x sporozoites = eight total).

Dogs & Cats, Pigs (C. suis), Humans (C. belli), Nonhuman primates (C. arctopitheci,C. callimico, and C. scorzai).
Most species oocysts measuring ~ 20-53 X 10-43 µm (animal ones being larger than C. belli).
Cystoisospora spp. (Cystoisosporiasis);
Oocysts (shed in feces);
~20-53 X 10-43 µm - Broadly oval, colorless to pinkish, no micropyle or micropylar cap.
Sporulated containing 1x2x4 architecture (2x sporocysts X 4x sporozoites = eight total).

Dogs & Cats, Pigs (C. suis), Humans (C. belli), Nonhuman primates (C. arctopitheci,C. callimico, and C. scorzai).
Most species oocysts measuring ~ 20-53 X 10-43 µm (animal ones being larger than C. belli).
Cystoisospora spp. (Cystoisosporiasis);

Cystoisospora suis;
Seen in neonatal pigs (5-15 days old).
Watery or greasy diarrhea, yellowish and foul smelling.
Clinical disease happens in 2 phases;
First wave: 4-6 days of age.
Second wave: 4-8 days later.
High morbidity, mortality variable.

Eimeria spp. (Coccidiosis);
Most species oocysts is ovoid to ellipsoidal, ~10-40 X 10-30 µm (vast range), smooth, distinct micropyle.
Unsporulated oocyst shed in feces contain 1x4x2 architecture (4x sporocysts X 2x sporozoites (eight total)).
Takes 1-2 days to sporulate and become infectious.

Eimeria bovis and E. zuernii (Coccidiosis of cattle);

horses and donkeys
Eimeria leukarti (Coccidiosis)
~80-88 X 55-59 µm, dark brown, watermelon shaped seed.

horses and donkeys
Eimeria leukarti (Coccidiosis)
~80-88 X 55-59 µm, dark brown, watermelon shaped seed.

horses and donkeys
Eimeria leukarti (Coccidiosis)
~80-88 X 55-59 µm, dark brown, watermelon shaped seed.

new world camelids
Eimeria macusaniensis
EMAC ~80-88 X 55-59 µm, pyriform, thick cell wall and micropyle and cap.

rabbit
Eimeria stiedae

rabbit
Eimeria stiedae

rabbit
Eimeria stiedae

mammals
Balantidium coli
Cysts (found in fecal floatation's usually);
Non-multiplying, non-motile with no cilia, environmentally resistant.
Smaller, spherical cysts (~40-70 x 40-60 µm).

mammals
Balantidium coli
Trophozoites (found in diarrhea);
~30–150 x 25–120 µm (largest protozoan parasite of humans).
Have both macronucleus and micronucleus.

Giardia duodenalis:
Trophozoites (found in small intestine and diarrhea);
~9–21 x 5–15 µm.
Pear-shaped, 2x nuclei, 4x pair of flagella, 2x median bodies, a ventral adhesive disk.
Cysts (found in fecal floatations usually);
~8-15 X 5-10 µm.
Ovoid to ellipsoid, possess a two-layered wall with 2–4 nuclei and internal fibrils (axonemes).

Giardia duodenalis:
Trophozoites (found in small intestine and diarrhea);
~9–21 x 5–15 µm.
Pear-shaped, 2x nuclei, 4x pair of flagella, 2x median bodies, a ventral adhesive disk.
Cysts (found in fecal floatations usually);
~8-15 X 5-10 µm.
Ovoid to ellipsoid, possess a two-layered wall with 2–4 nuclei and internal fibrils (axonemes).

Giardia duodenalis:
Trophozoites (found in small intestine and diarrhea);
~9–21 x 5–15 µm.
Pear-shaped, 2x nuclei, 4x pair of flagella, 2x median bodies, a ventral adhesive disk.
Cysts (found in fecal floatations usually);
~8-15 X 5-10 µm.
Ovoid to ellipsoid, possess a two-layered wall with 2–4 nuclei and internal fibrils (axonemes).

canines
Cystoisospora canis
34-40 X 28-32 µm

canines
Cystoisospora canis
34-40 X 28-32 µm

felines
Cystoisospora felis
38-51 X 27-39 µm

felines
Cystoisospora felis
38-51 X 27-39 µm

Cystoisospora ohioensis
20-27 × 15-24 um

Cystoisospora ohioensis
20-27 × 15-24 um

Cystoisospora rivolta
21-28 × 18-23 um
dark brown and watermelon shaped seed.

new world camelids
Eimeria ivitaensis
83–99 X 49–59 µm, ellipsoidal, not as thick, no micropylar cap
dark brown and watermelon shaped seed.

Cryptosporidium spp.
Oocysts (shed in feces);
~4-6 X 4.5-7 µm - No micropyle or micropylar cap, inner and outer walls are sealed closed by the suture.
Sporulated oocyst containing 1x0x4 architecture (0x sporocysts X 4x sporozoites total).
Cryptosporidium spp.
Oocysts (shed in feces);
~4-6 X 4.5-7 µm - No micropyle or micropylar cap, inner and outer walls are sealed closed by the suture.
Sporulated oocyst containing 1x0x4 architecture (0x sporocysts X 4x sporozoites total).

Cryptosporidium spp.
Oocysts (shed in feces);
~4-6 X 4.5-7 µm - No micropyle or micropylar cap, inner and outer walls are sealed closed by the suture.
Sporulated oocyst containing 1x0x4 architecture (0x sporocysts X 4x sporozoites total).

Cryptosporidium spp.
Oocysts (shed in feces);
~4-6 X 4.5-7 µm - No micropyle or micropylar cap, inner and outer walls are sealed closed by the suture.
Sporulated oocyst containing 1x0x4 architecture (0x sporocysts X 4x sporozoites total).

Cryptosporidium spp.
Oocysts (shed in feces);
~4-6 X 4.5-7 µm - No micropyle or micropylar cap, inner and outer walls are sealed closed by the suture.
Sporulated oocyst containing 1x0x4 architecture (0x sporocysts X 4x sporozoites total).

Cryptosporidium spp.
Oocysts (shed in feces);
~4-6 X 4.5-7 µm - No micropyle or micropylar cap, inner and outer walls are sealed closed by the suture.
Sporulated oocyst containing 1x0x4 architecture (0x sporocysts X 4x sporozoites total).